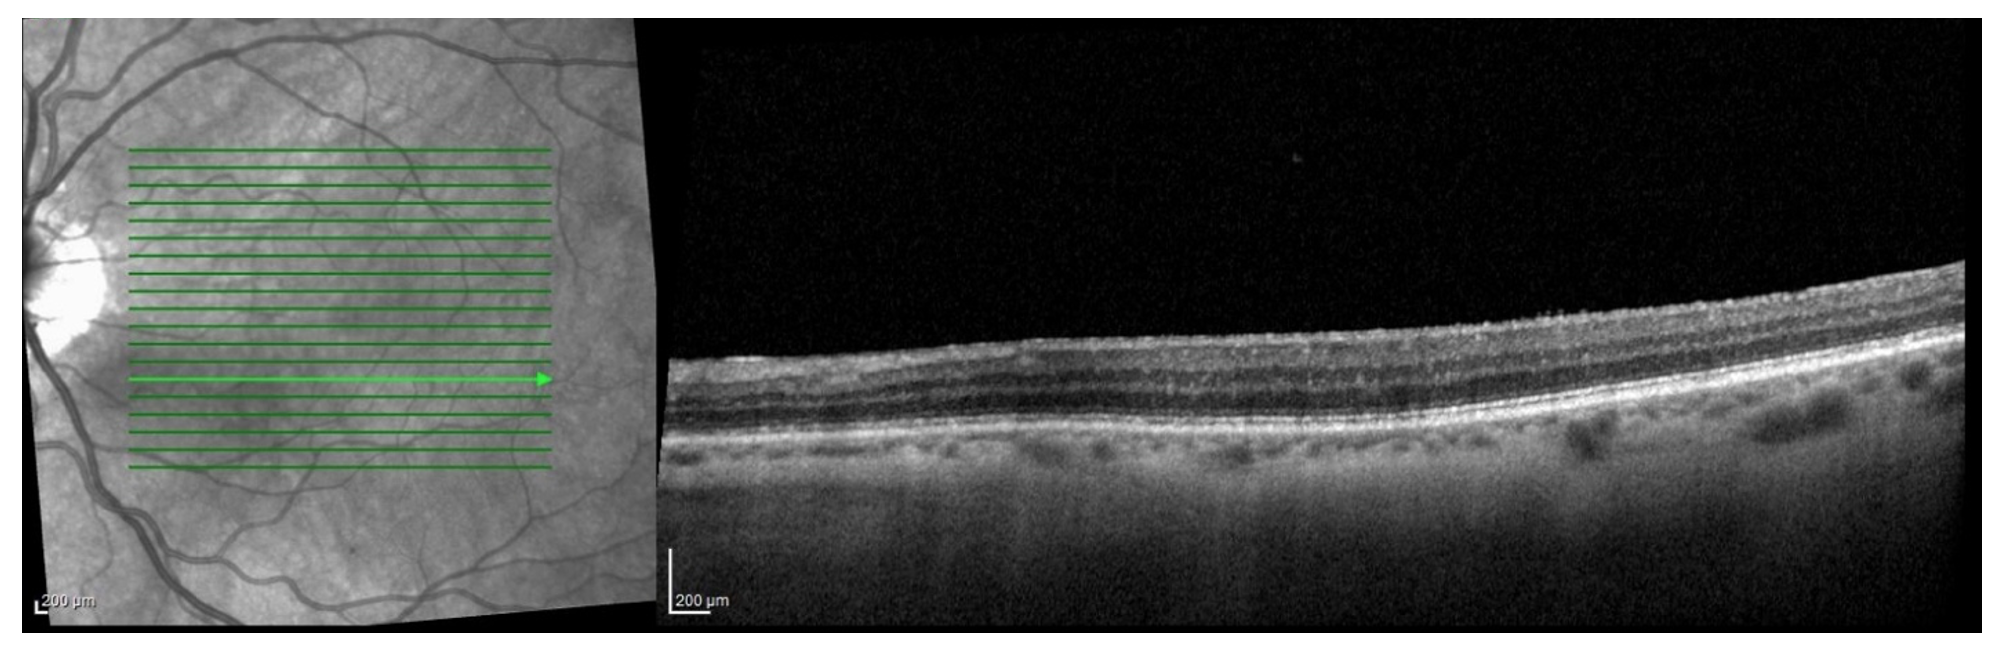

IMAGE OF THE MONTH: Q4 2025
A spotty puzzle


A 77-year-old female with history of cataracts, HTN, HLD, DM2, and aortic stenosis presents for new spots in the left eye. She denies flashes of light, photophobia and new floaters. Visual acuity is 20/40 OU (uncorrected) and anterior segment exam demonstrates trace nuclear sclerosis OU without vitreous cell in either eye. What is the diagnosis? What other diagnoses should be considered? How would you manage this patient?
DIAGNOSIS
Multiple evanescent white dot syndrome (MEWDS)
The differential diagnosis for multifocal white lesions in the posterior pole includes multiple evanescent white dot syndrome (MEWDS), acute posterior multifocal placoid pigment epitheliopathy (APMPPE), multifocal choroiditis with panuveitis (MCP), birdshot chorioretinopathy, sarcoidosis, infectious choroiditis such as syphilis, punctate inner choroidopathy (PIC), and masquerade syndromes such as lymphoma or metastatic lesions. A careful history, multimodal imaging, and exclusion of infectious and inflammatory etiologies are critical for accurate diagnosis.
The key to the diagnosis in this case was the fundus autofluorescence, which revealed numerous hyperautofluorescent lesions, predominantly in the posterior pole. Additionally, OCT through the characteristic lesions showed disruption of the ellipsoid zone with hyperreflective material extending into the outer retina, without subretinal fluid or significant RPE loss. A fluorescein angiography, while not obtained in this case, would typically reveal early punctate hyperfluorescence with late staining of the lesions. These findings, combined with the patient’s acute unliteral photopsias and scotomas, were most consistent with MEWDS.
MEWDS is typically a self-limited, monophasic inflammatory chorioretinopathy that affects young, otherwise healthy patients, often women, and is frequently preceded by a viral prodrome.1,2 Frequently, patients will endorse photopsias, and can be noted to have foveal granularity on slit lamp biomicroscopy. While most cases resolve spontaneously within weeks to months, rare reports describe recurrence or progression to other “white dot syndromes”.3 The acute presentation may mimic infectious posterior uveitis (e.g. syphilis, tuberculosis, viral retinitis) or inflammatory conditions (sarcoidosis, Vogt-Koyanagi-Harada disease), underscoring the important of targeted systemic workup to rule out vision or life-threatening causes.1
Although MEWDS carries an excellent visual prognosis in most cases, recognition is critical to avoid unnecessary interventions. MEWDS is generally self-resolving and there is limited data to support the use of corticosteroids or immune-modulating therapy. Patients should be counseled on the natural history and monitored with serial OCT and autofluorescence.
In this case, the patient had an unusual age demographic, did not endorse flashes, and did not recall a specific viral prodrome. However, the autofluorescence and OCT, along with the spontaneous improvement, were suggestive of a MEWDS-like syndrome. The patient was observed, and demonstrated improvement in the appearance, size, and autofluorescence of the lesions on subsequent imaging.
OCT on Presentation
FAF at 2 month Follow Up
OCT at 2 Month Follow Up
1. Jampol LM, Sieving PA, Pugh D, Fishman GA, Gilbert H. Multiple evanescent white dot syndrome. Arch Ophthalmol. 1984;102(5):671–674.
2. Marsiglia M, Gallego-Pinazo R, Cunha de Souza E, et al. Expanded clinical spectrum of multiple evanescent white dot syndrome with multimodal imaging. Retina. 2016;36(1 Suppl):S50–S64.
3. Wu JS, Lewis H. Multiple evanescent white dot syndrome: natural history and risk of recurrence. Retina. 1998;18(6):557–562.